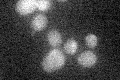
YHR001W-A
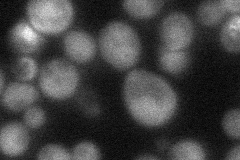
YHR001W-A
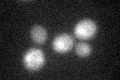
YHR001W-A

View description
Subunit of the ubiqunol-cytochrome c oxidoreductase complex which includes Cobp, Rip1p, Cyt1p, Cor1p, Qcr2p, Qcr6p, Qcr7p, Qcr8p, Qcr9p, and Qcr10p and comprises part of the mitochondrial respiratory chain
Localization:
Intensity:
Fold change:
Significance:
-
C’ GFP library in SD
below threshold17.68 -
N' NOP1pr-GFP in SD

cytosol75.1571 -
N' TEF2pr-mCherry in SD

cytosol71.0948 -
N' NATIVEpr-GFP in SD
cytosol36.0564 -
N' TEF2pr-VC and Cyto-VN in SD

below threshold25.5397 -
C’ GFP library in SD+DTT
cytosol16.630.94No -
C’ GFP library in SD+H2O2

cytosol16.330.92No -
C’ GFP library in Starvation Media

cytosol16.580.93No -
C’ GFP library on the background of Pup2-DaMP

below threshold -
C’ GFP library on the background of CCT mutant

below threshold15.5240.877483No
